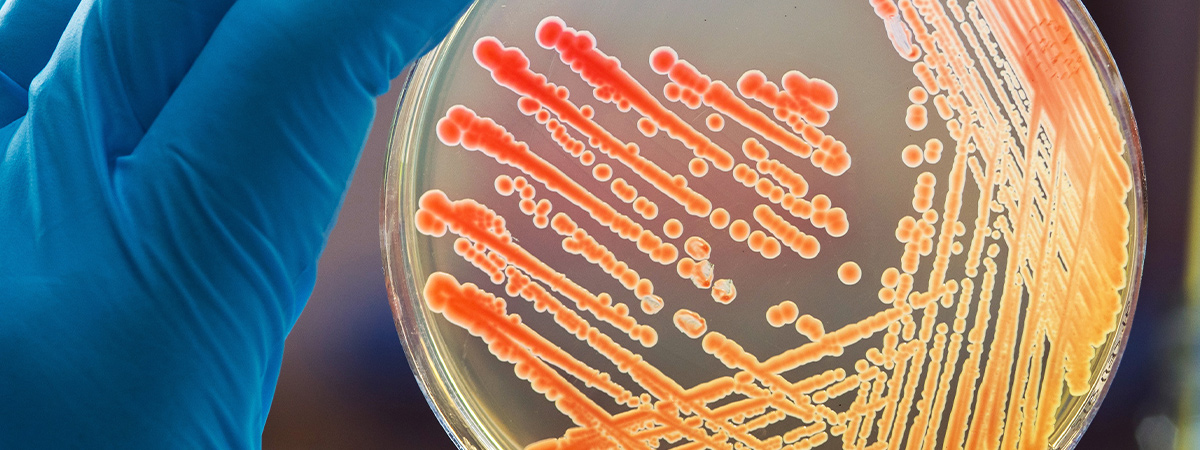

Resource Library


Resource Library
Take advantage of our vast library of complimentary learning materials and stay up to date on the latest in business software and best practices.

Additional Solutions
Sales Tax Automation
Be Prepared for 2020 Sales Tax Changes
Businesses of all sizes have had to scramble to keep up with changing tax liabilities, and it’s not expected to slow down. To help you prepare for 2020’s sales tax changes, we’ve brought in our tax expert partner Avalara.
Read more

Sage 300 ERP
Sage 300: Measuring Your Manufacturing Profitability
Watch this on-demand webcast to understand how an integrated manufacturing solution for Sage 300 gives you the peace of mind to know your actual cost to produce your goods, integrate with your purchasing & payables systems, as well as your quote, order and fulfillment processes.
Read more

WMS / Inventory
CRM Software
CRM for Manufacturers
In this white paper we outline three key operational improvements that can be realized using functions found in all of the best of breed manufacturing CRM solutions.
Read more

Sage 500 ERP
Sage X3
Better Budgeting, Forecasting & Planning in Sage X3 / Sage 500
Watch this on-demand webinar where together with our Sage ISV partner Prophix, we’ll highlight how to streamline your financial processes within Sage x3/500 – resulting in time saved, resources well-managed, and more time for you to focus on the things that really matter.
Read more

Criterion HCM
Non-Profit Solutions
Transformative HR Technology For Nonprofits
Watch this on-demand webinar to find out how an all-in-one Human Capital Management (HCM) solution can help your organization to be more effective at a lower cost.
Read more
Food and Beverage Industry
Sage X3
3 Things to Know About the FDA Smarter Food Safety Initiatives
Food recalls are up significantly causing the FDA to take action by instituting new traceability, record keeping, and data collection initiatives built on a platform of technology.
Read more

Sage HRMS
Fast & Focused: Tips for Sage HRMS Payroll Users
Join us to learn the latest tips and tricks to maximize the use of your Sage HRMS Payroll System. Several tips will be included, along with ideas form other users.
Read more

Sage HRMS
Risk-Free Migration to Sage HRMS
Time is running out for Sage Abra Suite users! Join us to learn how Net at Work can provide a foolproof migration from Abra to Sage HRMS. We will discuss techniques, timelines and approaches that will make your move to Sage HRMS as simple and error-free as possible.
Read more

Sage HRMS
Fast & Focused: New Hire HR Report
Crystal New Hire Reports will be today’s topic. We will be looking at both a human readable and electronic format report of new hire information.
Read more




